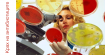

Може ли да се обърне процесът на стареене на човека и може ли да се победи ракът? Защо не – стига да удължим теломерите, заключават няколко пилотни изследвания в областта. Не се правя на интересен – и аз не знаех какво мери „теломерът”. Оказва се –нищо! Това са окончанията на хромозомите, които съставляват нашето ДНК. Те често се сравняват с пластмасовите краища на връзките на обувките, тъй като спират хромозомите от „разнищване” или сливане и така поддържат стабилен генетичния код.
Но всичко по реда си. Като говорим за спиране на стареенето, не става дума за фантастични нощни кремове или за билкова формула на вечната младост. Обнадеждаващо изследване показва, че всеобхватни промени в начина на живот - намаляване на стреса, подобряване на хранителния режим и умерени упражнения - могат да увеличат дължината на теломерите.
Всеки път, когато една клетка в тялото ни се дели, се разделят хромозомите (може да имате далечен спомен от часовете по биология) и теломерите стават по-къси и по-къси. След 50 до 70 цикъла, се стига до точката, когато клетките вече не могат да се делят и те стават неактивни (или "застаряващи") и умират. В този смисъл, дължината на теломерите е един от показателите за биологичната възраст. Късите теломери са също свързани с широк диапазон от болести на възрастта, включително рак, сърдечно-съдови заболявания и деменция.
Удължаването на теломерите не е въпрос на лично предпочитание. Какво може да направим все пак? Изследователи от Университета на Калифорния изучавали група от 10 мъже с рак на простатата и ги помолили да ядат диета на растителна основа, да правят упражнения и да управляват своето ниво на стрес с техники като медитация и йога. Дължината на теломерите при мъжете била измерена в началото и след пет години. Резултатите били сравнени с контролна група от 25 мъже, които не направили никакви промени в начина си на живот. Оказало се, че теломерите на контролната група са съкратени средно с 3% , а тези на „здравословната” група били удължени със средно 10%. Още един факт в подкрепа на здравословни начин на живот!
Понякога самите клетки започват да „защитават” дължината на теломерите - но това са отчаяни опити, защото става дума за ракови заболявания. Когато една клетка стане канцерогенна, тя започва да се дели по-често и нейните теломери бързо се скъсяват. Помните, че следва фатален край. Често пъти, тези клетки се опитват да избегнат смъртта като произвеждат ензима теломераза, който пречи на теломерите да станат още по-къси. Този ензим е характерен за младите клетки, но с възрастта, той не може да смогне да компенсира дължината на всички теломери при клетъчното делене. Лошото в случая с раковите клетки е, че ензимът удължава живота им като предпазва теломерите им и удължава тяхното размножаване. Това се случва при много видове рак - включително рак на панкреаса, на костите, рак на простатата, пикочния мехур, белите дробове, бъбреците и т.н.
Измерванете на теломеразата може да бъде начин за откриване на рак, според учените. Ако пък те открият начин да спрат засиленото производство на този ензим, то това би довело по-бързо да стареене и умиране на раковите клетки. Но съществуват и рискове. Блокиране на теломеразата ( и оттам деленото на клетките) може да увреди плодовитостта, зарастването на рани, производството на кръвни клетки и клетки на имунната система.

Коментари